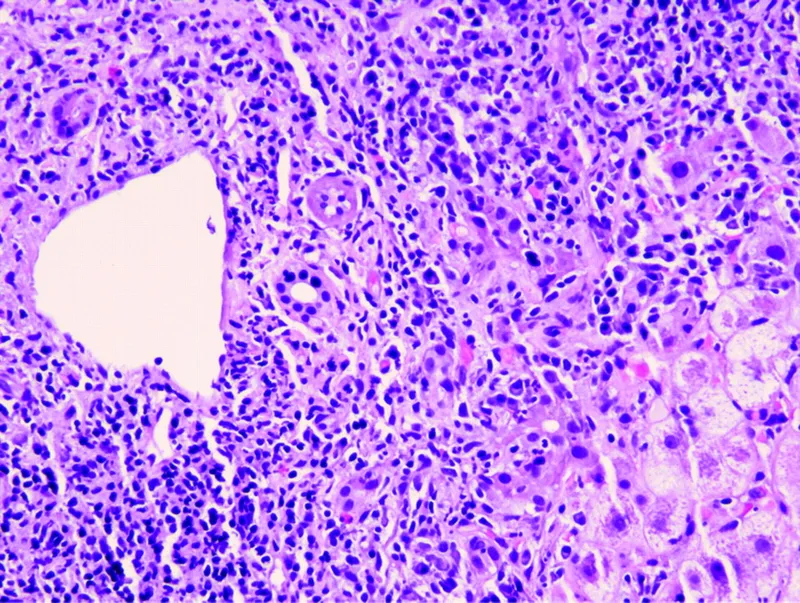
Histology of Drug-Induced Liver Injury (DILI)

DILI Basics - The Liver's Drug Problem
- A diagnosis of exclusion in acute liver injury of unknown cause.
- Two main types:
- Intrinsic (Predictable): Dose-dependent, short latency (e.g., Acetaminophen toxicity via NAPQI metabolite).
- Idiosyncratic (Unpredictable): Not dose-related, variable latency. Most common form (e.g., Augmentin, Isoniazid).
- 📌 Common Culprits: Antibiotics, Anticonvulsants, Acetaminophen, Allopurinol.
⭐ Hy's Law: Predicts severe DILI. Defined by hepatocellular injury (↑ ALT/AST >3x ULN) with ↑ Total Bilirubin >2x ULN, without cholestasis. Carries a 10-50% mortality risk.

Injury Patterns - A Tale of Two Cells
- Hepatocellular: Direct hepatocyte damage.
- Labs: Predominant ↑↑ ALT.
- Drugs: Acetaminophen, Isoniazid, Statins, Valproate.
- Cholestatic: Bile flow obstruction.
- Labs: Predominant ↑↑ ALP.
- Drugs: Augmentin, Anabolic steroids, OCPs.
- Mixed: Features of both.
Classification uses the R-value: $R = (ALT / ULN) / (ALP / ULN)$
- Hepatocellular: R ≥ 5
- Cholestatic: R ≤ 2
- Mixed: 2 < R < 5
⭐ Hy's Law: DILI causing hepatocellular jaundice (↑ Bilirubin) without initial cholestasis (normal ALP) indicates severe injury with >10% mortality risk.
The Detective Work - Diagnosis & Causality
- A diagnosis of exclusion requiring high suspicion and a meticulous drug/herb history (timing, dose, duration).
- Primary task: Rule out other causes (viral, autoimmune, alcoholic, metabolic, biliary obstruction).
- Calculate the R-value to classify injury pattern:
- $R = (ALT_{patient} / ALT_{ULN}) / (ALP_{patient} / ALP_{ULN})$
- Hepatocellular: R ≥ 5
- Cholestatic: R ≤ 2
- Mixed: 2 < R < 5
- Causality: Formally assessed with the Roussel Uclaf Causality Assessment Method (RUCAM).
⭐ Acetaminophen is the leading cause of drug-induced acute liver failure in the United States.

The Perp Lineup - Common Culprit Drugs
- Hepatocellular Necrosis (Direct & Idiosyncratic):
- Acetaminophen (dose-dependent), NSAIDs, Statins
- Isoniazid, Halothane, Valproate, Phenytoin
- Cholestatic Injury:
- Amoxicillin-clavulanate, Erythromycin
- Anabolic steroids, Oral contraceptives
- Other Patterns:
- Amiodarone, Methotrexate (steatohepatitis, fibrosis)
📌 Mnemonic "Rule of A's": Acetaminophen, Augmentin, Allopurinol, Anesthetics (Halothane), Amiodarone, Antiepileptics.
⭐ Amoxicillin-clavulanate is a classic cause of cholestatic DILI, which can have a delayed onset of weeks to months, even after discontinuing the drug.
Damage Control - Management & Prognosis
- Primary Therapy: Prompt withdrawal of the suspected offending drug is critical.
- Management Algorithm:
⭐ Hy's Law: Key prognostic indicator. Defined as hepatocellular injury (↑ALT/AST >3x ULN) with ↑Total Bilirubin >2x ULN, portending a 10-50% mortality risk.
- Drug-Induced Liver Injury (DILI) is a diagnosis of exclusion after ruling out other common causes of liver disease.
- Acetaminophen toxicity is the leading cause of acute liver failure in the U.S.; the antidote is N-acetylcysteine.
- Intrinsic DILI is predictable and dose-dependent (e.g., acetaminophen), whereas idiosyncratic DILI is unpredictable.
- Key culprits include amoxicillin-clavulanate, isoniazid, anticonvulsants (valproate, phenytoin), and statins.
- The cornerstone of management is prompt withdrawal of the offending drug.
Unlock the full lesson and continue reading
Signup to continue reading this lesson and unlimited access questions, flashcards, AI notes, and more